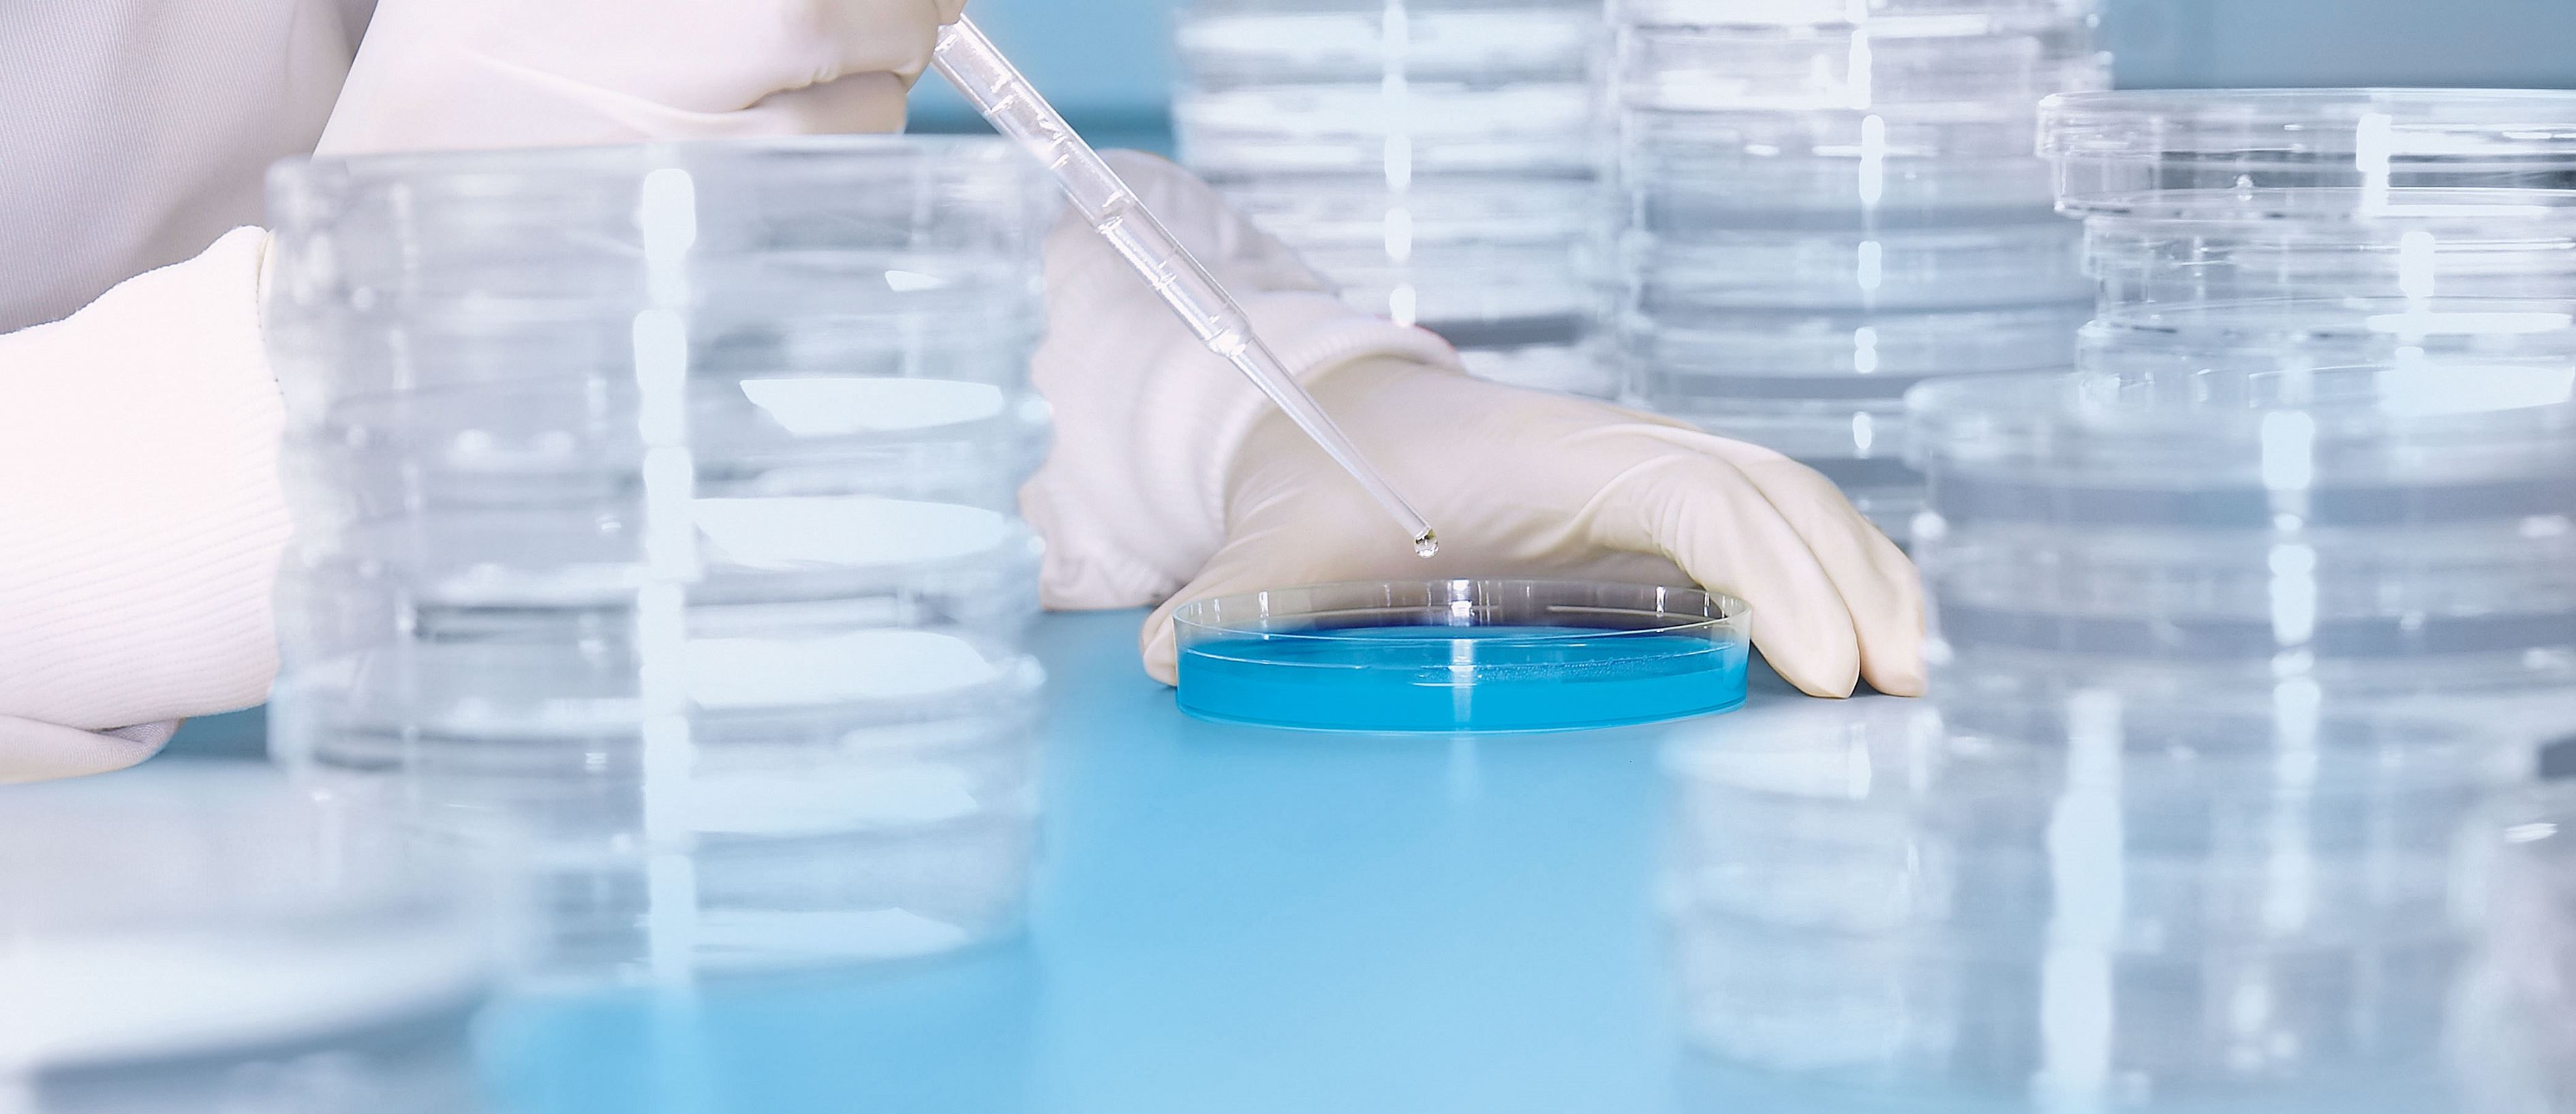
Hygienelabor.jpg Hygienelabor.jpg
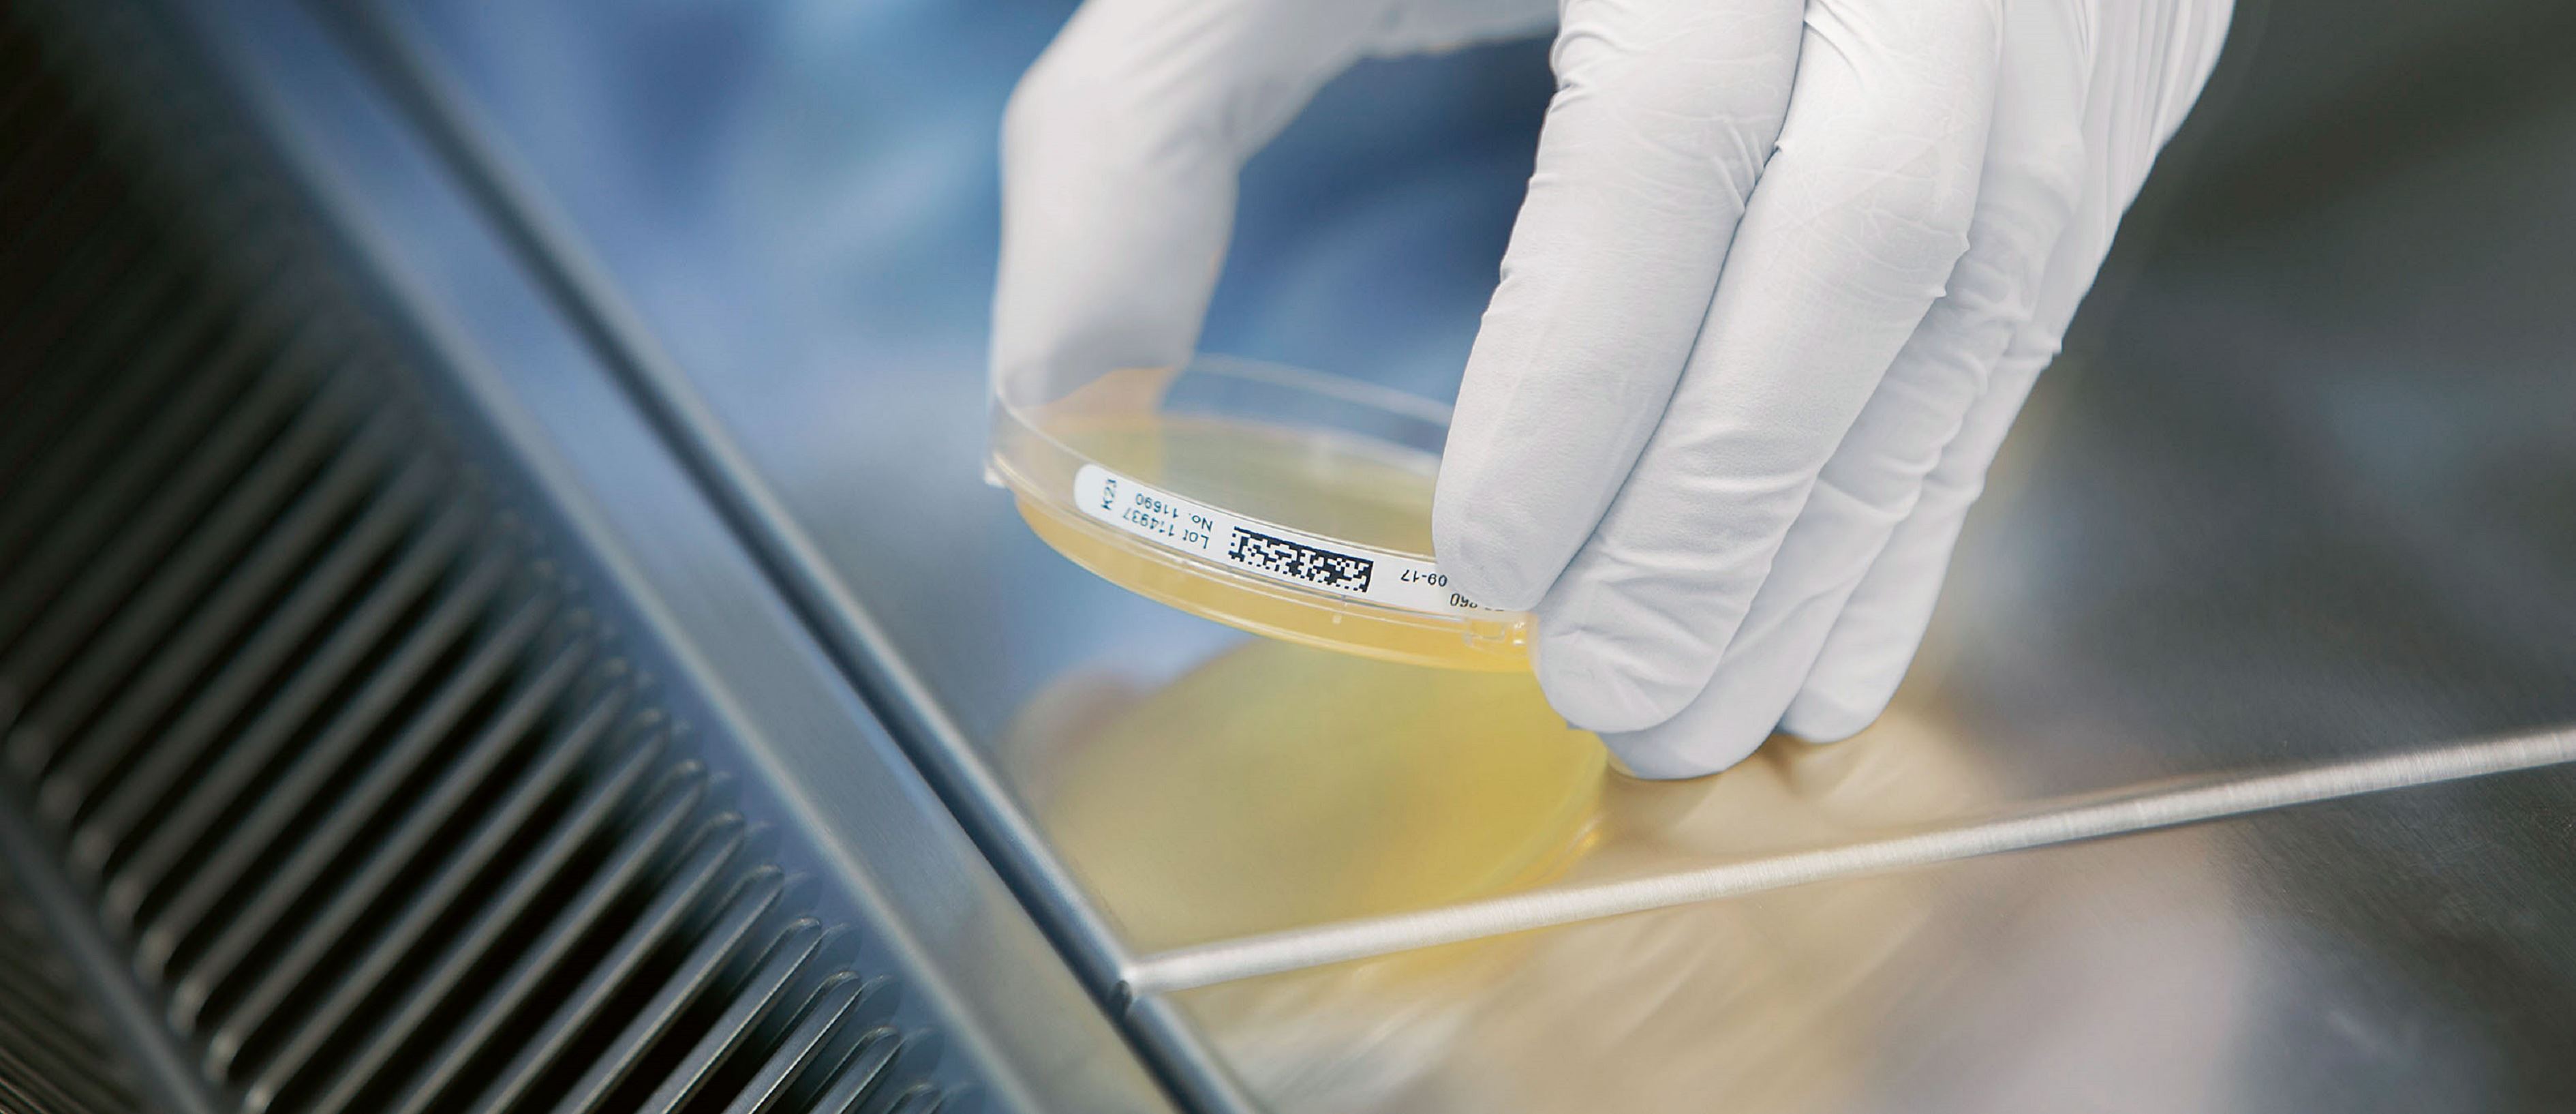
Hygiene-Monitoring.jpg Hygiene-Monitoring.jpg

Enzler Hygiene AG
Wir bieten ganzheitliche Reinigungs- und Hygienekonzepte.
Unser Dienstleistungsangebot
Individuell und angepasst auf Ihre Bedürfnisse.
News
Aktuelles zu unserer Arbeit.

Service
Hygieneberatung
Die Anforderungen an Reinigung und Hygiene sind in ihrer Gesamtheit komplex und in der Praxis nicht immer leicht umsetzbar. Das Einhalten gesetzlicher Vorgaben und Hygieneverordnungen sowie deren Integration in den Praxisalltag können aufwendig und kostenintensiv sein. Unser Enzlerh-tec-Team besitzt das nötige Expertenwissen und unterstützt Sie in Ihrem Reinigungsmanagement.
Zum ServiceService
Hygienekonzept
Ein umfassendes Hygienekonzept ermöglicht, Gegebenheiten zu analysieren und zu verändern. Das Hygieneverhalten der Mitarbeitenden ist genau festgelegt, kann jederzeit überprüft und bei Bedarf angepasst werden. Als Hygienespezialisten behalten wir die komplette Hygienekette im Auge. Wir zeigen Handlungsbedarf und Verbesserungspotenzial auf und unterstützen Sie beim Erstellen der Dokumentation.
Zum ServiceService
Hygieneaudit
Die Hygiene ist ein grundlegendes Qualitätsmerkmal von medizinischen Betrieben und Bereichen mit hohen regulatorischen Anforderungen. Ein Hygieneaudit ist eine systematische und unabhängige Untersuchung, die feststellt, ob die qualitätsbezogenen Tätigkeiten und damit zusammenhängende Ereignisse den Anforderungen und Hygieneverordnungen entsprechen.
Zum ServiceService
Management-Support
Der digitale Wandel hat unseren Alltag fest im Griff. Jederzeit online verfügbare Informationen und Dienstleistungen, mobile Apps und intelligente Smartphones sind zur Selbstverständlichkeit geworden und beeinflussen unsere Arbeitsprozesse. Die Digitalisierung von Raumdaten bietet auch für das Reinigungs- und Hygienemanagement neue Möglichkeiten und Herausforderungen.
Zum ServiceService
Reinigung im Gesundheitswesen
Reinigung und Hygiene sind zwei Begriffe, die in direkter Abhängigkeit zueinander stehen. Die Hygieneanforderungen in Institutionen des Gesundheitswesens nehmen stetig zu und werden für alle Beteiligten zu einem entscheidenden Erfolgsfaktor. Wir von der Enzler Hygiene AG haben uns seit Jahren auf die anspruchsvollen Reinigungs- und Hygienedienstleistungen in Spitälern, Reha-Kliniken und Heimen spezialisiert.
Zum ServiceService
OP-Reinigung
Die Operationsräume sind oft das Herzstück eines Spitals und zählen zu den sensiblen Hygienebereichen. Um die hohen regulatorischen Anforderungen an OP-Räume zu erfüllen, ist die strikte Einhaltung der Hygienevorschriften erforderlich. Diesen Räumen gebührt in Sachen Reinigung und Hygiene unsere besondere Aufmerksamkeit.
Zum ServiceService
Zytostatika-Entfernung
Zytostatika, die vor allem im Kampf gegen Krebserkrankungen eingesetzt werden, können die Oberflächen in Behandlungszimmern kontaminieren. Damit medizinisches und pflegendes Personal nicht durch stetigen Kontakt mit Zytostatika gesundheitlichen Risiken ausgesetzt wird, ist die Spezialreinigung dieser Räume durch Fachspezialisten erforderlich.
Zum ServiceService
Reinraum-Reinigung
In Reinräumen werden Produkte einer grossen Bandbreite produziert – von Halbleitern über Medizinprodukte bis hin zu Pharma- und Biotechprodukten. Reinräume sollen dafür sorgen, dass weder Produkte verunreinigt werden noch Stoffe aus dem Produktionsprozess unkontrolliert in die Umwelt gelangen.
Zum ServiceService
Qualifizierung von Reinraum-Systemen
Von der Pharma- und Biotech-Industrie bis zum OP-Saal – die Luftqualität spielt im Reinraum-Bereich und in Bereichen mit hohen hygienischen Ansprüchen eine wesentliche Rolle. Wir sorgen dafür, dass die Qualität der Luft den vorgegebenen Normen und Richtlinien entspricht.
Zum ServiceService
Chemische und biologische Dekontamination
Kontaminationen mit Mikroorganismen wie Bakterien, Pilzen und Viren können zu gesundheitlichen Problemen beim Menschen führen und stellen eine Gefahr für Produkte und Umwelt dar. Die Beseitigung der Verunreinigung erfordert profundes Wissen und ein perfektes Zusammenspiel aller Projektpartner.
Zum ServiceService
H₂O₂-Biodekontamination
Durch gezielte Biodekontamination mit Wasserstoffperoxid können verunreinigte Produktions- und Reinräume sowie Anlagen auch an schwer zugänglichen Stellen desinfiziert werden.
Zum ServiceService
Geruchsneutralisation
Gerüche beeinflussen unsere Lebensqualität erheblich. Der Mensch ist rund um die Uhr Geruchsemissionen ausgesetzt. Sie kommen praktisch überall vor und werden meist durch externe Einflüsse verursacht. Deren Beseitigung ist allerdings äusserst komplex und es bedarf hierbei Know-how von Fachspezialisten.
Zum ServiceService
Sanierung von Wasserschäden
Wasserschäden in Gebäuden erfordern nicht nur ein rasches, sondern vor allem ein kompetentes Vorgehen zur Verhinderung von Folgeschäden. Darüber hinaus ist es besonders wichtig, mikrobiologische Kontaminationen, die durch Schimmelpilzsporen entstehen können, zu verhindern oder nachhaltig zu beseitigen.
Zum ServiceService
Hygiene-Monitoring
Mikrobiologische Hygienekontrollen von Reinräumen und anderen hygienisch sensiblen Bereichen durch regelmässiges Monitoring dienen dazu, die Qualität des eigenen Hygienemanagements mit handfesten Daten zu belegen. Letztlich dient Hygiene-Monitoring der Qualitätssicherung von Produkten ebenso wie der Sicherheit von Menschen und Umwelt.
Zum ServiceService
Ausbildung und Hygieneschulung
Die Tatsache, dass der Grundstein für eine einwandfreie Arbeitsausführung in der Aus- und Weiterbildung liegt, gilt auch für die Reinigung und Hygiene. In vielen Bereichen gelten spezielle Anforderungen und hygienische Vorgaben, die von den Reinigungsmitarbeitenden Fachkenntnisse, Sorgfalt und Engagement verlangen.
Zum ServiceService
Ausbildungsinhalt Reinigung im Gesundheitswesen
In Spitälern und Pflegeeinrichtungen braucht es mehr als die optische Sauberkeit von Räumen und Oberflächen. Desinfektion und die Vermeidung von Kreuzkontaminationen spielen hierbei eine entscheidende Rolle.
Zum ServiceService
Ausbildungsinhalt GMP- und Reinraum-Reinigung
Eine solide GMP-Grundausbildung und regelmässige Schulungen sind Voraussetzungen für Reinigungsmitarbeitende, um die in Reinräumen geltenden hohen hygienischen und regulatorischen Vorgaben einhalten zu können.
Zum Service- Vorheriger Service
- Nächster Service

Wie viel Reinigung ist nötig?
Die Enzler Hygiene AG ist Ihr zuverlässiger Partner.
- vom Ermitteln Ihrer Bedürfnisse
- über die detaillierte Planung
- bis hin zur kompetenten Auftragsausführung

